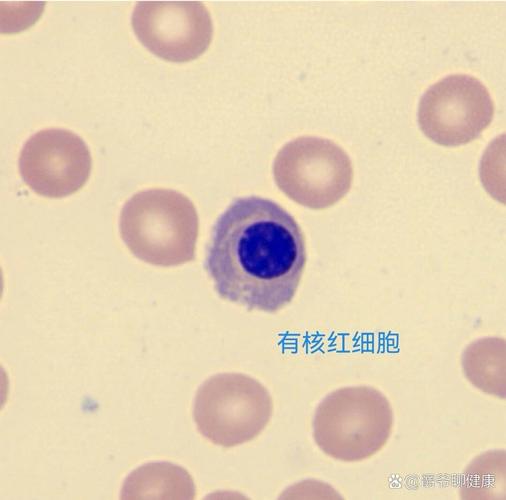
雞的紅血球有細胞核嗎

雞的紅血球有細胞核嗎?解析禽類紅血球的獨特結構與奧秘
您是否曾經在進行生物實驗,或是單純地對動物世界感到好奇時,腦中浮現過這個問題:「雞的紅血球有細胞核嗎?」相信許多人對於哺乳類動物紅血球無細胞核的特性比較熟悉,但對於像是雞這樣的鳥類,情況可就不太一樣了。答案是肯定的,雞的紅血球確實有細胞核!這可是禽類紅血球和哺乳類紅血球最顯著的區別之一,也揭示了演化過程中結構上的精妙適應。今天,我們就要來深入探討一下,為何雞的紅血球會有細胞核,以及這對牠們的生理機能有什麼樣的影響。
Table of Contents
為何雞的紅血球會帶有細胞核?
這個問題的答案,其實藏在生物演化的長河中。經過數百萬年的演化,不同的物種發展出了各自獨特的生存策略和生理結構。相較於哺乳類動物,雞所屬的鳥類,牠們的紅血球之所以保留了細胞核,有其演化上的優勢和考量。
從結構上來說,具有細胞核的紅血球,細胞質內的空間會受到細胞核的佔據,相對來說,攜帶氧氣的血紅素含量可能會比無核紅血球來得少一些。但是,擁有細胞核的紅血球,其實可以透過細胞核內的DNA,進行一定程度的基因表現和蛋白質合成。這意味著,當身體面臨某些特定的生理壓力,例如缺氧時,禽類紅血球或許能更靈活地進行調節,以應對變化。
此外,科學家們也提出,有細胞核的紅血球,在細胞分裂和再生方面的能力,可能比無核的紅血球更為活躍。這對於需要經常進行高強度活動,且體溫相對較高的鳥類來說,能夠快速補充因活動消耗或損傷的紅血球,維持充足的氧氣供應,是非常重要的。
雞的紅血球結構解析
讓我們來細看一下雞的紅血球,究竟長什麼樣子。
- 細胞核: 這是最關鍵的特徵!雞的紅血球細胞內,有一個明顯的、橢圓形的細胞核,通常位於細胞的中央或略為偏一側。這個細胞核包含著細胞的遺傳物質DNA。
- 血紅素: 和所有攜帶氧氣的紅血球一樣,雞的紅血球細胞質內富含血紅素,這是讓紅血球呈現紅色的關鍵蛋白質,負責結合和運送氧氣。
- 細胞質: 除了細胞核和血紅素,細胞質還包含其他的細胞器,但相對哺乳類動物的紅血球來說,結構是比較簡化的。
- 形狀: 雞的紅血球通常呈橢圓形,兩端較為尖細。
與之相比,哺乳類動物的紅血球,例如我們人類的,在成熟過程中會逐漸喪失細胞核以及大部分的細胞器,演化成雙凹圓盤狀。這種結構的優勢在於,最大化了細胞的表面積與體積比,有利於氧氣的快速交換,同時也讓紅血球更具彈性,能夠順利通過狹窄的微血管。然而,這種「簡化」也意味著牠們無法自行合成蛋白質,一旦受損,就必須依賴骨髓產生新的紅血球。
有細胞核對雞的生理有何影響?
雞的紅血球帶有細胞核,這在牠們的生理機能上,確實帶來了一些與哺乳類動物不同的地方。我個人認為,這反映了演化對於不同生活環境和需求的適應,是很令人驚嘆的!
1. 氧氣運輸效率的權衡
如前所述,有細胞核的存在,確實會佔用部分細胞質空間,理論上會影響紅血球攜帶血紅素的總量。但這並不意味著雞的氧氣運輸效率就比較差。牠們的紅血球,可能在其他方面做了補償,例如更高的血紅素濃度,或是其他調控機制。
而且,鳥類通常擁有非常高效的呼吸系統,其肺部的結構(如氣囊系統)能夠進行單向氣流,大大提高了氧氣的獲取效率。這種高效的氧氣獲取,或許能夠彌補紅血球本身攜氧能力上的潛在限制。
2. 紅血球的再生與修復能力
我認為,這可能是雞的紅血球帶核最為關鍵的優勢之一。由於細胞核的存在,禽類紅血球保有了一定的自我維持和修復能力。當紅血球因為老化、物理損傷或其他因素而受損時,牠們的細胞核裡的DNA就可以指導細胞進行一些基本的蛋白質合成,進行細胞的修復。更重要的是,這些有核紅血球本身就可以進行細胞分裂,這大大增強了牠們在需要時快速補充紅血球的能力。
想想看,鳥類經常需要飛行,這是一項非常耗費體力的活動,對氧氣的需求量極大。如果身體能夠快速且有效地製造新的紅血球來應對這種高強度的活動,對於維持其生存至關重要。
3. 代謝與體溫調節
鳥類的代謝率普遍較高,體溫也比哺乳動物高。這意味著牠們對氧氣的需求量非常大,需要高效的氧氣運輸系統來支持牠們的生理活動。有細胞核的紅血球,或許透過其可調節的代謝途徑,能夠更靈活地適應這種高代謝的需求。
與哺乳類紅血球的比較
為了更清楚地理解雞的紅血球為何特殊,我們可以用一個表格來比較牠們與哺乳類紅血球的主要差異:
| 特徵 | 雞的紅血球 | 哺乳類紅血球 |
|---|---|---|
| 細胞核 | 有 | 無 |
| 細胞器 | 保留部分,如粒線體(成熟紅血球中較少) | 幾乎無 |
| 主要功能 | 氧氣運輸,並具有一定的自我維持和再生能力 | 主要為氧氣運輸,依賴骨髓製造 |
| 形狀 | 橢圓形,兩端較尖 | 雙凹圓盤狀 |
| 壽命 | 相對較短 | 相對較長 |
| 產生部位 | 骨髓 | 骨髓 |
從這個表格可以看出,這兩種紅血球在結構上的差異,反映了牠們在演化路徑上的不同選擇,各自發展出了適合自身生存環境的優勢。
總結:演化的智慧結晶
所以,回到最初的問題:「雞的紅血球有細胞核嗎?」答案是肯定的,牠們擁有。這並不是一種「不完全」的紅血球,而是演化過程中一個非常聰明的適應性改變。有細胞核的紅血球,賦予了雞類在氧氣運輸、再生能力以及對生理壓力反應上的獨特優勢,完美地支援了牠們活躍的生活方式。
每次看到這些生物學上的細節,我都覺得非常佩服大自然的鬼斧神工。看似微小的結構差異,背後卻蘊含著如此深刻的演化邏輯和生理意義。希望今天的分享,能讓您對雞的紅血球以及禽類紅血球的奧秘,有更深入的了解!
常見相關問題與詳細解答
1. 為什麼不是所有的動物紅血球都有細胞核?
這個問題涉及到生物演化過程中的「適者生存」原則。不同的物種,為了適應各自獨特的生存環境和生理需求,會發展出不同的結構和功能。哺乳類動物的紅血球演化出無核的特性,主要是為了最大化氧氣運輸的效率和紅血球的柔韌性。牠們體積小,可以通過極為狹窄的微血管,並且表面積大,有利於氣體交換。相對的,無核的紅血球無法自行合成蛋白質,也無法進行分裂,其壽命相對較短,必須依賴骨髓不斷產生新的紅血球來維持體內循環。而對於像雞這樣的鳥類,牠們的飛行生活以及較高的代謝率,可能使得紅血球具備一定的自我修復和再生能力,以及對生理變化的更靈活響應,成為牠們演化的優勢。
2. 雞的紅血球有細胞核,那牠們的血紅素濃度會比較低嗎?
這是一個很好的問題!從細胞結構上來看,細胞核確實會佔據一部分細胞體積,理論上可能會影響單位紅血球能攜帶血紅素的總量。然而,實際情況是,雞的紅血球在單位體積內的血紅素濃度,可能與哺乳類動物的紅血球有著相當的效率。更重要的是,鳥類作為一個整體,擁有非常高效的呼吸系統,像是牠們獨特的肺部結構,能夠實現連續的氣流交換,這大大提高了氧氣的吸收效率。因此,即使紅血球本身攜帶的氧氣量有一定權衡,但整體來看,鳥類能夠獲得充足的氧氣供應,以滿足牠們高代謝的需求。
3. 雞的紅血球細胞核對牠們的壽命有什麼影響?
由於雞的紅血球有細胞核,牠們保有了一定的自我更新和修復能力。這意味著,在某些情況下,牠們的紅血球細胞可能可以進行一些細胞內的修復工作,或是參與到更廣泛的細胞生理調節中。然而,相對哺乳類動物來說,禽類紅血球的壽命通常會短一些。這可能是因為牠們處於一個需要快速、高強度活動的生理狀態,紅血球的更新換代速度較快,以便隨時保持最佳的氧氣運輸狀態。有細胞核的紅血球,其壽命約為20-45天,而哺乳類動物的紅血球壽命則可長達120天左右。所以,這是一個結構與功能的權衡,並非單純的優劣之分。
4. 所有的鳥類紅血球都有細胞核嗎?
是的,根據目前的生物學研究,幾乎所有的鳥類,包括雞在內,牠們成熟的紅血球都帶有細胞核。這是鳥類紅血球的一個普遍特徵,與牠們在演化上的親緣關係以及共同的生理需求有關。這個特徵將鳥類與哺乳類動物的紅血球區分開來,是一個重要的分類學和生理學指標。
5. 雞的紅血球有細胞核,那在實驗室中觀察時會有什麼不同?
如果您在顯微鏡下觀察雞的紅血球,最明顯的區別就是會看到一個清晰、橢圓形的細胞核,通常在細胞的中間。這與觀察哺乳類動物的紅血球時,只能看到一個沒有細胞核的、中間略凹的圓盤狀細胞,是截然不同的。觀察雞的紅血球時,您可能會發現牠們的細胞形狀也比哺乳類動物的紅血球來得更為細長和尖銳一些。這個細胞核的存在,也意味著在進行某些細胞培養或分子生物學實驗時,可能會需要考慮到這個結構的影響。